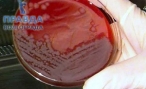

Наркополицейские в минувшем месяце установили факты распространения на территории страны нового психоактивного высокотоксического вещества MDMB (N)-Bz-F. По своему воздействию на человека он похож на CBL-2201. После обнаружения специалисты приступили к началу процедуре включению их в списки подконтрольных.
Наркополицейские в минувшем месяце установили факты распространения на территории страны нового психоактивного высокотоксического вещества MDMB (N)-Bz-F. По своему воздействию на человека он похож на CBL-2201. После обнаружения специалисты приступили к началу процедуре включению их в списки подконтрольных.
За три месяца ФСКН России удалось внести CBL-2201 вместе с двумя другими веществами в Перечень наркотических средств, психотропных подлежащих контролю в Российской Федерации.
Как стало известно, одно из этих веществ в составе «спайсов» стало причиной массовых отравлений этой осенью. Более двух тысяч наркоманов обратились за помощью, более половины из них положили в больницы. А сорок человек так и не удалось спасти.
Также полицейским удалось обезвредить девять региональных преступных группировок и задержать 32 оптовых сбытчика «спайсов». При этом из незаконного оборота изъято более 100 кг психоактивных веществ, что приравнено к 3,5 миллионам наркотических доз. К сожалению, среди них есть наркотические вещества, пока не запрещенные к обороту.
Преступная схема была сложной и продуманной до мелочей. Связь между сбытчиками и получателями обеспечивалась под псевдонимами, было использовано огромное количество SIM-карт. В «работе» преступниками использовались свыше десяти тысяч электронных кошельков.
Всего за последние три года в стране установлены меры контроля в отношении почти 780 новых психоактивных веществ